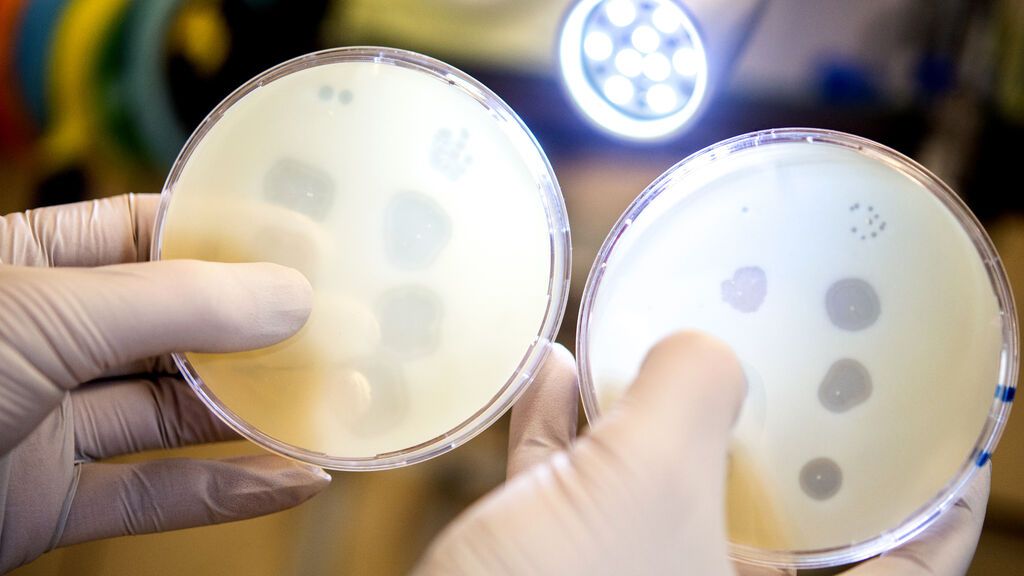
220120 soc fago atacnado

La fagoterapia salva a una mujer de una bacteria resistente a antibióticos

La paciente sufrió un politraumatismo tras un atentado y en el hospital se infectó con la bacteria Klebsiella pneumoniae
Un tratamiento combinado con fago ha acabado con esta bacteria resistente a los antibióticos
Los bacteriófagos son los virus que infectan y parasitan a las bacterias matándolas
MadridA sus 30 años Karen Northshield ha vuelto a nacer gracias a la fagoterapia. En 2016 sufrió un politraumatismo durante un atentado suicida en el aeropuerto de Bruselas y, durante la recuperación, una bacteria infectó una de sus extremidades. La infección que provocó puso en peligro su vida porque era una de esas bacterias resistentes a los antibióticos sobre las que alerta la OMS.
Seis años después del accidente hace vida normal gracias a un tratamiento experimental al que recurrieron sus médicos: usaron fagos (virus que infectan bacterias). Sus médicos han publicado el caso en la revista científica Nature Communications.
“Tres años después del tratamiento combinado fago-antibiótico, la paciente ha recuperado la deambulación y la movilidad, generalmente con la ayuda de muletas, y participa en eventos deportivos como el ciclismo”, reza el informe.

El caso
Tras el atentado, Northshiel ingresó en la UCI del Hospital Erasmo de la capital belga. Al llegar, sufrió una parada cardíaca causada por un shock hemorrágico, había perdido mucha sangre por las heridas del flanco izquierdo del muslo. Después de una agresiva intervención multidisciplinaria, en la que tuvieron que amputarle parte de la pierna, los médicos consiguieron estabilizarla.
Pero lo peor estaba por llegar, a los cuatro días una bacteria puso su vida en peligro. Era de la especie Klebsiella pneumoniae, las conocidas como resistentes, había infectado su muslo izquierdo y su cuerpo no respondía al tratamiento.
Una de las amenazas para la salud
La bacteria que le había infectado era una de los seis patógenos bacterianos altamente virulentos y resistentes a los antibióticos reconocido por la Organización Mundial de la Salud (OMS).
Un peligroso grupo al que se le conoce por el acrónimo ESKAPE: (Enterococcus faecium , Staphylococcus aureus , Klebsiella pneumoniae , Acinetobacter baumannii , Pseudomonas aeruginosa y Enterobacter).
La OMS calcula que las infecciones que provocan se ceban en pacientes hospitalizados y podrían matarán a 10 millones de personas al año en 2050. En España se calcula que anualmente suponen más muertes que las provocadas por los accidentes de tráfico.
Por eso el tratamiento al que sometieron a Karen y que ha acabado con la peligrosa bacteria ha llamado tanto la atención.
Inicialmente, los médicos aplicaron los antibióticos más conocidos como amoxicilina/clavulanato y posteriormente siguieron con piperacilina/tazobactam. Pero no respondía. Así que hicieron un cultivo bacteriano de las biopsias quirúrgicas que mostró una flora polimicrobiana, consistente en "Enterococcus faecium", "Pseudomonas aeruginosa", "Enterobacter cloacae" y "Klebsiella pneumoniae". Hallado el problema empezó la búsqueda de solución.
Al ver que el tratamiento antibiótico a largo plazo no lograba curarla (lo que se tradujo en un retraso en la cicatrización de la herida y una ausencia total de consolidación del fémur), los clínicos decidieron recurrir a la terapia con fagos, es decir recurrir a virus especializados en matar bacterias y acabar así con la infección de Karen.
Un largo camino lleno de dudas
El comité ético del Hospital Erasme autorizó el uso de terapia experimental con fagos en noviembre de 2016 e incluso la paciente firmó una autorización, pero ante la falta de consenso entre los médicos tratantes, todo se suspendió.
“Los fagos funcionan muy bien, inyectas un poco a un paciente y cada vez que llegan a una bacteria se reproducen, es decir, cuantas más bacterias encuentran más virus generan. En Europa están permitidos como tratamiento compasivo, pero no rutinario. El motivo es que los fagos pueden modificar su ADN con el tiempo y esto da miedo a las agencias reguladoras. Sus consecuencias si mutan son impredecibles”, explica Bruno González, asesor de la OM en un artículo de Redacción Médica.
Hasta que en febrero de 2018 (702 días después de la lesión)y ante un callejón sin salida terapéutico, los médicos retornaron el tema.
Estaba en aguas residuales
Antes los autores seleccionaron y adaptaron un bacteriófago para la eliminación óptima de la bacteria específico para la cepa de K. pneumoniae de la paciente.
Para que funcione el tratamiento hay que buscar los mejores virus contra esta bacteria, algo que no es sencillo porque son la entidad biológica más numerosa de la Tierra.
El equipo médico analizó el genoma de la bacteria que infectaban a Karen y se envió al mayor banco de fagos del mundo, que se encuentra en Georgia donde encontraron que el mejor para este caso se encontraba en una muestra procedente de aguas residuales de la región tailandesa de Tbilis.
Prepararon los virus para la terapia y se la administraron a la paciente en la zona infectada.
Tres meses después de la intervención quirúrgica del día 702 y del inicio de la terapia combinada fago-antibiótico, el estado general de Karen había mejorado, la herida estaba cicatrizando y no se encontró ninguna evidencia de infección bacteriana.
años después del tratamiento (seis desde el atentado) la paciente anda con muletas y hasta monta en bicicleta.
¿Cómo funciona el fago?
Los bacteriófagos son los virus que infectan y parasitan a las bacterias. Se les puede detectar en cualquier ecosistema, habiéndose calculado que son capaces de infectar a más de 140 géneros bacterianos distintos, se considera además que son las entidades biológicas más abundantes del planeta
Para que funcione en un caso concreto hay que encontrar el adecuado.
Una vez seleccionado y tratado en el laboratorio para adaptarlos al caso, se aplica en la superficie del paciente y allí se multiplica dentro de las bacterias que encuentra y las va eliminando.
Es un tratamiento que se conoce desde hace tiempo.
No es un tratamiento desconocido
En los últimos años se han publicado numerosos artículos científicos que han demostrado el gran potencial de este tratamiento. A día de hoy, existen bastantes más casos de tratamientos exitosos, como el que se publicó hace un par de años en la revista Nature Medicine: una paciente británica de 15 años cpn fibrosis quística e infección diseminada por Mycobacterium abscessus se curó completamente mediante la administración intravenosa de un cóctel de tres fagos modificados en el laboratorio que atacaron eficazmente a la cepa de Mycobacterium abscessus que estaba dañando sus órganos vitales.
Desde el CSIC aseguran que, en España, nos encontramos en una buena posición para adoptar estas nuevas terapias.
“La fagoterapia, con sus debilidades y dificultades, va a ser en el futuro cercano al menos una de las principales soluciones para luchar contra las bacterias resistentes, como alternativa o complemento a los antibióticos. Nuestra sociedad necesita tener ahora este debate y adelantarse a la ola de las pandemias por venir”, aseguran científcos del grupo de trabajo sobre Terapia Fágica del CSIC.
